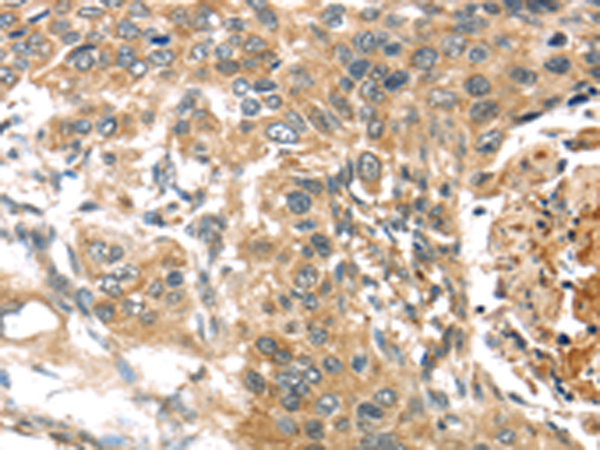

-
分类: 科研抗体货号: P12315别名: TORC2; TORC-2应用: WB反应种属: Human, Mouse, Rat
-
分类: 科研抗体货号: P12340别名: CT78; TSPY; DYS14; pJA923/CT78应用: IHC反应种属: Human
-
分类: 科研抗体货号: P12330别名: C8FW; GIG2; TRB1; GIG-2; SKIP1; TRB-1应用: IHC反应种属: Human, Mouse
-
分类: 科研抗体货号: P12339别名:应用: IHC反应种属: Human
-
分类: 科研抗体货号: P12344别名: TSC21; C2orf51应用: WB反应种属: Human
-
分类: 科研抗体货号: P12329别名: NG2; MCSP; MCSPG; MSK16; CSPG4A; HMW-MAA; MEL-CSPG应用: WB,IHC反应种属: Human, Mouse, Rat
-
分类: 科研抗体货号: P12338别名: TSPYL应用: WB反应种属: Human, Mouse
-
分类: 科研抗体货号: P12343别名: smg-10; KIAA0406应用: IHC反应种属: Human, Mouse
-
分类: 科研抗体货号: P12354别名: DCUBP应用: IHC反应种属: Human, Mouse
-
分类: 科研抗体货号: P12337别名: CT20; TSP50应用: WB,IHC反应种属: Human

鄂公网安备42018502007531号
鄂公网安备42018502007531号

